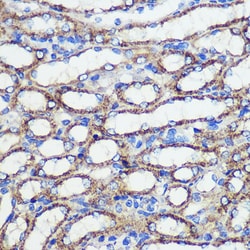
Invitrogen SND1 Polyclonal Antibody 100 &mu;L; Unconjugated:Antibodies,

missing translation for 'onlineSavingsMsg'
Learn More
Learn More
Invitrogen™ SND1 Polyclonal Antibody


Rabbit Polyclonal Antibody
Brand: Invitrogen™ PA576889
This item is not returnable.
View return policy
Description
The antibody was affinity-purified from rabbit antiserum by affinity-chromatography using epitope-specific immunogen and the purity is > 95% (by SDS-PAGE).
SND1/P100 (staphylococcal nuclease and tudor domain containing 1), also known as TudorSN, functions in the Pim-1 regulation of Myb activity and acts as a transcriptional activator of EBNA-2. It also interacts with EAV, NSP1, GTF2E1 and GTF2E2, and forms a ternary complex with Stat6 and POLR2A. The staphylococcal nuclease-like (SN)-domains directly interact with amino acids 1099-1758 of CBP. SND1/P100 plays an important role in the assembly of Stat6 transcriptome and stimulates IL-4-dependent transcription by mediating interaction between Stat6 and CBP.
Specifications
| SND1 | |
| Polyclonal | |
| Unconjugated | |
| Snd1 | |
| 100 kDa coactivator; 4SNc-Tudor domain protein; 4SNc-Tudor domain protein long form; 4SNc-Tudor domain protein short form; AL033314; EBNA-2 co-activator (100kD); EBNA2 coactivator p100; p100; p100 co-activator; p100 co-activator variant 1; p100 EBNA2 co-activator; p100L; P100-like protein short variant; p100S; similar to Homo sapiens EBNA-2 co-activator (100kDa coactivator); p105 coactivator; SN4TDR; SND p102; SND1; snd1 protein; SND1-BRAF fusion; staphylococcal nuclease and tudor domain containing 1; staphylococcal nuclease domain containing 1; staphylococcal nuclease domain-containing protein 1; TDRD11; testis tissue sperm-binding protein Li 82P; tudor domain-containing protein 11; TudorSN; Tudor-SN; wu:fc27g10 | |
| Rabbit | |
| Antigen Affinity Chromatography | |
| RUO | |
| 27044, 56463, 64635 | |
| Store at 4°C short term. For long term storage, store at -20°C, avoiding freeze/thaw cycles. | |
| Liquid |
| Immunohistochemistry (Paraffin), Immunoprecipitation, Western Blot, Immunocytochemistry | |
| 1 mg/mL | |
| PBS with 50% glycerol and 0.02% sodium azide; pH 7.2 | |
| Q66X93, Q78PY7, Q7KZF4 | |
| Snd1 | |
| Recombinant full length Human SND1. | |
| 100 μL | |
| Primary | |
| Human, Mouse, Rat | |
| Antibody | |
| IgG |
Product Content Correction
Your input is important to us. Please complete this form to provide feedback related to the content on this product.
Product Title
Spot an opportunity for improvement?Share a Content Correction